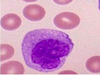

PATHO - Réponses tissulaires aux aggressions Flashcards
(97 cards)
Définir : Inflammation
une réaction complexe face à des agents infectieux mais aussi en réponse à des cellules et tissus endommagés, habituellement nécrotiques.Elle survient dans des tissus vascularisés et consiste en des phénomènes vasculaires et cellulaires et elle s’accompagne parfois d’une réaction systémique.
Nommez les signes cliniques de l’inflammation/ Signes cardinaux de l’inflammation
- Rougeur
- Oedème enflure
- Douleur
- Perte de fonction
- Chaleur
La réactionin flammatoire peut être (2):
- aiguë
- chronique
Définir : Réaction inflammatoire aiguë
survenant dans les secondes ou minutes après l’agression, durant quelques minutes, heures ou jours.
Définir : Réaction inflammatoire chronique
durant des semaines, mois et mêmes parfois des années.
Nommez les stimuli inflammatoires
- infections
- nécrose tissulaire
- corps étrangers
- réactions immunitaires
L’inflammation aiguë comporte trois (3) composantes:
- Modification dans le calibre des vaisseaux permettant une augmentation du flot sanguin localement. (vasodilatation) (1er Changement vasculaire)
- Modification structurale de la microcirculation permettant aux protéines plasmatiques et aux globules blancs de quitter la circulation. (Augmentation perméabilité vasculaire) (2e Changement vasculaire)
- Émigration, accumulation et activation des globules blancs au site inflammatoire. (Réponse cellulaire)
Au cours de la phase initiale de la réaction inflammatoire, qu’est-ce qui se passe avec la pression hydrostatique? Qu’est-ce que ça entraîne?
Au cours de la phase initiale de la réaction inflammatoire, l’augmentation de la pression hydrostatique dans les vaisseaux entraîne une petite sortie de liquide vers le milieu extra-vasculaire. Il est constitué d’eau, de sels et de quelques protéines de faible poids moléculaire. Il est appelé transsudat.Par la suite, d’autres facteurs conduisent à un augmentation de la perméabilité vasculaire.
Qu’est-ce qui cause la rougeur (érythème) et chaleur dans la réaciton d’inflammation?
congestion
Les changements vasculaires sont de deux ordres:
- Modification du calibre des vaisseaux
- Modification de la perméabilité vasculaire
Il existe cinq (5) mécanismes pouvant être responsable de l’augmentation de la perméabilité vasculaire selon le type d’agression et l’évolution dans le temps de la réaction inflammatoire:
- Formation d’espaces entre les cellules endothéliales des veinules par rétraction (le plus fréquent)
- Dommage direct à l’endothélium
- Dommage endothélial causé par les globules blancs et leurs produits de sécrétion
- Transcytose (canaux intra-cellulaires dans les cellules endothéliales)
- Nouveaux vaisseaux durant la réparation
Modification de la perméabilité vasculaire qui est considérée comme une réponse immédiate transitoire
Formation d’espaces entre les cellules endothéliales des veinules par rétraction (le plus fréquent)
Modification de la perméabilité vasculaire qui est considérée comme une réponse immédiate soutenue
Dommage direct à l’endothélium
Modification de la perméabilité vasculaire qui est considérée comme une réponse tardive et prolongée
- Dommage endothélial causé par les globules blancs et leurs produits de sécrétion
- Transcytose (canaux intra-cellulaires dans les cellules endothéliales)
- Nouveaux vaisseaux durant la réparation
Expliquez la stase sanguine
Passage d’eau et de sels conduisant à la formation de l’œdème local et passage de protéines incluant le fibrinogène et les immunoglobulines
Expliquez cette image

Passage des globules blancs (leucocytes) du vaisseau vers le milieu extra-vasculaire endommagé.Le fibrinogène,protéine soluble, se polymérise en fibres insolubles (fibrine), emprisonnant les bactéries et servant de support aux leucocytes.
Nommez les cellules inflammatoires
- Polynucléaire neutrophile
- Monocytes
- Lymphocytes (B et T)
Décrire : Polynucléaire
une cellule dont la vie est courte, ne survivant que quelques heures lorsque dans les tissus. Lorsqu’il meurt, par apoptose, il libère dans le milieu ambiant ses enzymes servant à dégrader les tissus endommagés et tuer les bactéries présentes.
Décrire : Macrophage
vient éventuellement en aide aux polynucléaires. Il a un pouvoir phagocytaire et bactéricide très développé. Il vit beaucoup plus longuement.
Énumérez les événements en ordre chronologique de la réponse cellulaire
- La margination et le roulement
- L’adhésion, l’agrégation et la migration entre les cellules endothéliales
- La migration dans le tissu interstitiel vers un stimulus chimiotactique
- La phagocytose et la dégranulation
Margination et roulement
- La stase sanguine favorise la margination et le roulement des leucocytes sur l’endothélium par l’intermédiaire de molécules appelées sélectines.
- Normalement, ces molécules d’adhésion ne sont pas présentes ou le sont en faible quantité au niveau des leucocytes et des cellules endothéliales.
- Quelques minutes après l’exposition à certains médiateurs chimiques de l’inflammation, elles sont abondamment exprimées par les deux types de cellules.
Expliquez l’étape de la réponse cellulaire : Adhésion et agrégation
La ferme adhésion entre les leucocytes et les cellules endothéliales se produit grâce à l’interaction de molécules adhésives exprimées par les leucocytes (intégrines) et les cellules endothéliales (ICAM ET VCAM).
Expliquez l’étape de la réponse cellulaire : Migration
La migration trans-endothéliale (diapédèse) se produit au niveau veinulaire grâce à une autre famille de molécules adhésives appelées PECAM-1. Les cellules migrent au travers de l’endothélium grâce à la formation de pseudopodes.
Définir : Chimiotactisme
Dans le milieu extra-vasculaire, les cellules inflammatoires migrent vers le site inflammatoire attirées par des substances dites «chimiotactiques ».
Ce phénomène s’appelle chimiotactisme.
Ces facteurs sont aussi responsables d’activer les polynucléaires et ainsi favoriser leur rôle de phagocytose.